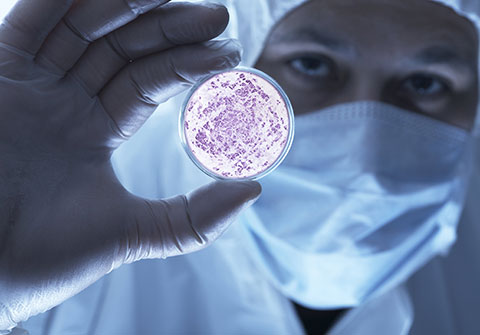

-

In memoriam: Arturo Muga
-

Azúcar y edulcorantes ¿Qué debo saber?
-

Athletic zuri ta gorria, zu zara nagusia, baina zertan? Gizonezko futbol profesionalaren gaitasun (im)mobilizatzaileari buruzko hausnarketa soziologikoa
-

En busca de un entorno alimentario universitario más saludable
-

Iñigo Ugedo Vicario: «Nos involucraremos activamente en los procesos de cambio universitario»
Conferencia: 'Candida auris, el hongo que ha causado una alerta sanitaria internacional'
Cuándo y dónde
04/04/2017 04/04/2017, 19:00 - 19:23
Lugar
Auditorio - Azkuna Zentroa
Arriquibar Plaza 4. -48010- Bilbao (Bizkaia)
Descripción
En los últimos meses, varias agencias nacionales e internacionales han emitido diferentes alertas sobre la expansión de un tipo de hongo, denominado Candida auris, que causa graves infecciones en pacientes hospitalarios críticos. Se trata de un agente infeccioso difícil de identificar y muy resistente a los fármacos existentes que puede provocar elevadas tasas de mortalidad. Su mayor incidencia hasta la fecha se ha producido en países como España, Dinamarca o EE.UU.
Guillermo Quindós, catedrático de Microbiología en la UPV/EHU, hablará sobre este organismo en una conferencia titulada "Candida auris, el hongo que ha causado una alerta sanitaria internacional".
Esta charla tendrá lugar el próximo 4 de abril en Azkuna Zentroa (Bilbao) y se impartirá en castellano. Forma parte del ciclo de conferencias Zientziateka, que organizan todos los meses la Cátedra de Cultura Científica de la UPV/EHU y Azkuna Zentroa para divulgar asuntos científicos de actualidad.
Las entradas deben recogerse en el punto de información de Azkuna Zentroa. El acceso es gratuito.


